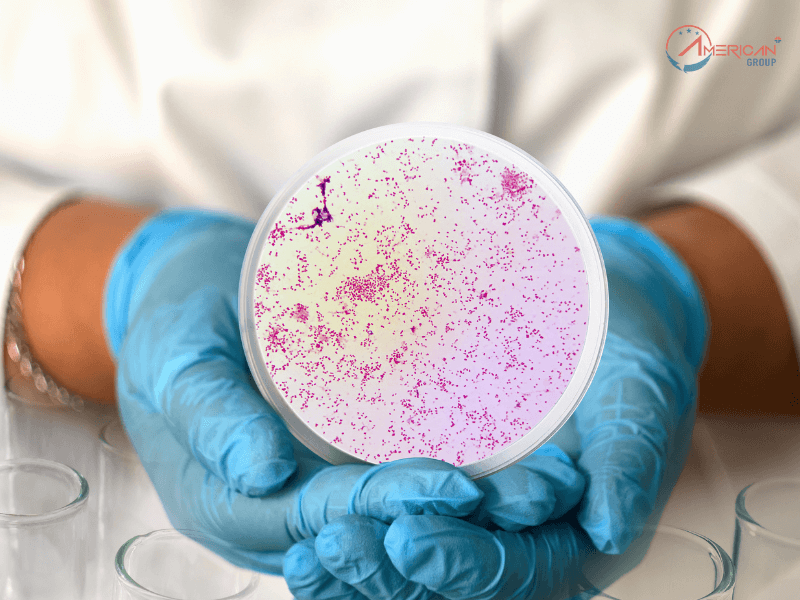
Danh Sách Bệnh Không Được Chấp Thuận Định Cư Mỹ Cập Nhật 2024 Bệnh giang mai giai đoạn truyền nhiễm (Syphilis)

Tin EB-5
Danh Sách Bệnh Không Được Chấp Thuận Định Cư Mỹ Cập Nhật 2024
Giấc mơ định cư Mỹ là khát khao của hàng triệu người trên toàn thế giới. Tuy nhiên, việc đạt được visa nhập cư không phải là điều dễ dàng, nhất là đối với những người mắc các bệnh nhất định. Trong năm 2024, chính phủ Mỹ sẽ thực hiện những điều chỉnh trong quy định liên quan đến các bệnh không được được phép định cư.
Bài viết sau đây sẽ cung cấp một danh sách đầy đủ và chi tiết về các bệnh không được chấp thuận định cư Mỹ trong năm 2024
Bệnh truyền nhiễm ảnh hưởng đến cộng đồng
Luật nhập cư Mỹ quy định nghiêm ngặt đối với người mang các bệnh truyền nhiễm có nguy cơ ảnh hưởng đến sức khỏe cộng đồng đều không được chấp nhận định cư Mỹ. Để bảo vệ sức khỏe của người dân, Bộ Y tế và Dịch vụ Nhân sinh Mỹ (HHS) đã ban hành danh sách các bệnh truyền nhiễm cần kiểm tra y tế bắt buộc đối với người nhập cư.
Xem thêm: Tầm Quan Trọng Của Cố Vấn Nhập Cư Trong Quy Trình EB-5
Bệnh lao loại A (Tuberculosis)

Trong năm 2024, những trường hợp mắc bệnh lao loại A không chấp nhận định cư Mỹ. Đây là dạng lao có triệu chứng rõ ràng và tiềm năng lây nhiễm cao, có thể gây nguy hiểm cho sức khỏe cộng đồng. Những người mắc bệnh lao loại A sẽ bị từ chối cấp thị thực nhập cư Mỹ.
Tất cả những người nộp đơn định cư Mỹ từ 2 tuổi trở lên đều phải thực hiện xét nghiệm sàng lọc bệnh lao. Đối với trẻ em dưới 2 tuổi, xét nghiệm sàng lọc bệnh lao chỉ được yêu cầu khi có triệu chứng nghi ngờ mắc bệnh lao hoặc khi trẻ được xác định nhiễm HIV. Trong trường hợp đã từng mắc bệnh lao, người nộp đơn phải chứng minh tình trạng sức khỏe của họ đã được kiểm soát và không còn khả năng lây nhiễm bệnh lao đến người khác
Xem thêm: 5 Bước Đăng Ký Trường Công Khi Qua Định Cư Mỹ
Bệnh giang mai giai đoạn truyền nhiễm (Syphilis)
Giang mai là một bệnh lây truyền qua đường tình dục không được chấp thuận định cư Mỹ năm 2024. Người nộp đơn có thể được yêu cầu xét nghiệm huyết thanh tìm bệnh giang mai tùy thuộc vào độ tuổi của người nộp đơn và các yếu tố khác do Trung tâm Kiểm soát và Phòng ngừa Dịch bệnh Mỹ (CDC) quy định.
Những người từng mắc bệnh cần chứng minh rằng họ đã hoàn thành quá trình điều trị và không còn khả năng truyền bệnh cho cộng đồng. Lưu ý, những người đang trong quá trình điều trị giang mai, nếu có kết quả xét nghiệm âm tính và không còn nguy cơ lây nhiễm, vẫn có thể được xem xét cấp visa định cư.
Xem thêm: Bảng Xếp Hạng Hộ Chiếu Quyền Lực Nhất Thế Giới Năm 2024
Bệnh lậu (Gonorrhea)
Vào năm 2024, những trường hợp mắc bệnh lậu đang trong giai đoạn có khả năng lây nhiễm sẽ không chấp nhận định cư Mỹ. Điều này tương tự như quy định đối với bệnh giang mai, chỉ những người trong giai đoạn lây nhiễm mới không đủ điều kiện cấp visa.
Người xin định cư phải nộp kết quả xét nghiệm chứng minh họ không nhiễm lậu. Trong trường hợp đã từng mắc bệnh, hồ sơ cần bao gồm bằng chứng về việc đã hoàn thành điều trị và không còn khả năng lây nhiễm bệnh. Đối với những người đang được điều trị lậu vẫn có thể được xem xét cấp visa định cư, miễn chứng minh được họ không còn là mối nguy cơ lây nhiễm bệnh cho cộng đồng
Xem thêm: Thẻ Xanh Mỹ: Sự Khác Biệt Giữa Thẻ Xanh Có Điều Kiện Và Vĩnh Viễn
Bệnh phong truyền nhiễm (Hansen’s Disease)
Một trong những bệnh truyền nhiễm tiếp theo không được chấp nhận định cư Mỹ năm 2024 là bệnh phong, căn bệnh từng được xem là “sát thủ thầm lặng” trong lịch sử, gây ảnh hưởng nghiêm trọng tới sức khỏe và có khả năng lây lan cao. Quá trình sàng lọc bệnh phong đòi hỏi việc thu thập thông tin tiền sử y khoa, cũng như các chẩn đoán trước đây và hiện tại của bệnh nhân. Khám sức khỏe định cư bắt buộc phải kiểm tra các triệu chứng và tổn thương da có thể liên quan đến bệnh phong
Trường hợp đã từng mắc bệnh, người nộp đơn phải chứng minh rằng họ đã được điều trị thành công và không còn là mối đe dọa lây nhiễm đối với cộng đồng. Ngay cả khi đang trong quá trình điều trị, nếu kết quả xét nghiệm âm tính, người nộp đơn có thể được xem xét cấp visa, miễn là họ không còn nguy cơ lây bệnh
Xem thêm: Vì Sao Định Cư Mỹ Được Xem Là Một Lựa Chọn Hấp Dẫn
Rối loạn thể chất hoặc tinh thần kèm hành vi có hại
Hiện tại hoặc có tiền sử rối loạn, kèm theo hành vi có hại hoặc nguy cơ tái diễn, gây đe dọa tài sản, sự an toàn hoặc phúc lợi của người khác
Đối với yêu cầu định cư Mỹ năm 2024, các rối loạn thể chất hoặc tinh thần có liên quan đến hành vi có hại không được chấp nhận. Điều này áp dụng cho những trường hợp có tiền sử hoặc hiện tại mắc rối loạn, nếu đi kèm với hành vi gây nguy hiểm cho tài sản, an toàn, hoặc phúc lợi của người khác.
Các rối loạn tâm thần như tâm thần phân liệt, rối loạn lưỡng cực, hoặc trầm cảm nghiêm trọng, nếu có hành vi bạo lực hoặc nguy cơ tái phát, có thể dẫn đến việc từ chối cấp visa nhập cư.
Người xin định cư phải cung cấp kết quả khám sức khỏe tâm thần chứng minh họ không mắc rối loạn nào có hại hoặc nguy hiểm. Nếu đã từng mắc bệnh, họ cần chứng minh đã được điều trị ổn định và không còn nguy cơ tái phát.
Xem thêm: Điều Kiện Và Quy Trình Cấp Thẻ Xanh EB-5
Rối loạn nhân cách kèm hành vi nguy hiểm
Ngoài ra, các rối loạn nhân cách kèm theo hành vi nguy hiểm cũng không được chấp nhận. Những người mắc rối loạn nhân cách chống đối, bất ổn, hoặc các rối loạn khác kèm theo hành vi bạo lực sẽ không đủ điều kiện cấp visa nhập cư.
Xem thêm: Tất Tần Tật Về Yêu Cầu Nguồn Vốn EB-5
Lạm dụng ma túy hoặc nghiện ma túy
Những trường hợp bị phát hiện lạm dụng hoặc nghiện ma túy sẽ không được chấp thuận nhập cư Mỹ. Điều này áp dụng cho những người có chứng rối loạn sử dụng chất gây nghiện hiện tại hoặc các rối loạn liên quan đến việc sử dụng các chất được quản lý theo Đạo luật về các chất bị kiểm soát.
Tuy nhiên, người nộp đơn có tiền sử lạm dụng hoặc nghiện ma túy có thể được xem xét lại nếu họ có thể chứng minh tình trạng của mình đã được thuyên giảm. Để làm điều này, họ cần phải trải qua một cuộc kiểm tra sức khỏe bởi một bác sĩ dân sự được chỉ định để xác nhận tình trạng sức khỏe không còn là mối đe dọa cho cộng đồng.
Xem thêm: Cập Nhật Mới Nhất Về Chi Phí Cho Chương Trình EB-5 Năm 2024
Bị HIV, Viêm gan B có đi Mỹ được không?

Từ ngày 04/01/2010, HIV không còn được coi là một bệnh truyền nhiễm ảnh hưởng đến cộng đồng theo quy định của Bộ Y tế và Dịch vụ Nhân sinh Mỹ (HHS). Do đó, HIV không nằm trong số các bệnh truyền nhiễm cấm định cư tại Mỹ.
Ngoài ra, viêm gan B và C cũng không còn nằm trong danh sách cấm nhập cảnh vào Mỹ vì lý do truyền nhiễm kể từ năm 2019. Xem thêm tại đây
Vì vậy, việc kiểm tra sức khỏe là một phần không thể thiếu trong quy trình định cư tại Mỹ, nhằm đảm bảo rằng không có nguy cơ bệnh tật nào từ người nhập cư có thể ảnh hưởng đến cộng đồng. Những trường hợp được xác định mắc bệnh nằm trong danh sách cấm sẽ không được phép định cư. Nếu người xin định cư mắc một trong những bệnh này, họ nên tiến hành điều trị để có cơ hội tiếp tục quá trình định cư tại Mỹ.
Xem thêm: Yêu Cầu Việc Làm Đối Với Chương Trình EB-5
Đồng hành cùng American Plus – Định cư Mỹ thông qua visa EB-5
Quyền lợi khi định cư Mỹ:
– Gia đình (vợ/chồng, con cái phụ thuộc dưới 21 tuổi) được cấp thẻ xanh Mỹ
– Gia đình hưởng quyền lợi an sinh xã hội, giáo dục như công dân Mỹ
– Con cái miễn học phí tới cấp phổ thông, hưởng trợ cấp và ưu đãi học phí đại học, cao học như sinh viên bản xứ
– Gia đình tự do làm việc, sinh sống, học tập tại bất cứ nơi nào trên nước Mỹ
– Cơ hội nhập tịch Mỹ
Quý Khách hàng quan tâm và mong muốn tìm hiểu về cơ hội làm việc và định cư Mỹ, vui lòng liên hệ đội ngũ APG (American Plus) theo hotline 094 806 4444 để được chuyên gia di trú và luật sư quốc tế hàng đầu tư vấn tham gia chương trình EB-5, đảm bảo tỷ lệ thành công 100%.

Quan tâm và cần hỗ trợ, hãy gọi Hotline 0948064444.
Tầng 18.09, Tòa nhà OT2 - Sài Gòn Royal
34 - 35 Bến Vân Đồn, Phường Xóm Chiếu, TP.HCM
094 806 4444
[email protected]
Quan tâm
Tin Mỹ
USCIS Ban Hành Chính Sách Chụp Ảnh Mới
Tin EB-5 Tin Mỹ
Chi Tiết Về Chương Trình Thẻ Vàng Và So Sánh Với EB-5
Lịch Chiếu Khán Mỹ
Lịch Chiếu Khán Di Dân Mỹ 1/2026
Tin Mỹ
Mỹ Thêm 7 Nước Vào Danh Sách Cấm Nhập Cảnh
Tin EB-5
Dự Án EB-5 CMB Nhóm 90 Hillwood Treeline Nhận I-526E
Tin EB-5
Visa EB-5 So Với E-2 Và L-1A: Loại Nào Phù Hợp Với Bạn?